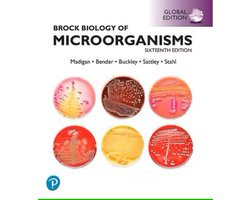
Omslag van Brock Biology of Microorganisms Biology, 16th Global Edition + Mastering Biology with Pearson eText

Boeken zoals: Brock Biology of Microorganisms, Global Edition
Tips voor lezers van Michael Madigan
Heb je Brock Biology of Microorganisms, Global Edition gelezen? Of ben je fan van de boeken van Michael Madigan? Dan vind je hieronder een aantal leestips die ook werden gezocht door lezers van 'Brock Biology of Microorganisms, Global Edition'.
Brock Biology of Microorganisms Biology, 16th Global Edition + Mastering Biology with Pearson eText
ISBN 9781292405230
Authoritative. Accurate. Accessible. Brock Biology of Microorganisms setsthe standard for accuracy ...
€ 82.11


Brock Biology Of Microorganisms
ISBN 9781292018317
An introduction to microbiology for biology and microbiology majors. Helping Today's Students Learn ...
€ 24.95

Molecular Biology Of The Cell
ISBN 9780393884852
The definitive text in cell biology now with the Digital Problems Book in Smartwork ...
€ 84.99

Chemistry, Global Edition
ISBN 9781292336145
This title is a Pearson Global Edition. The Editorial team at Pearson has worked closely with educators ...
€ 59.95
Brock Biology of Microorganisms, Global Edition
